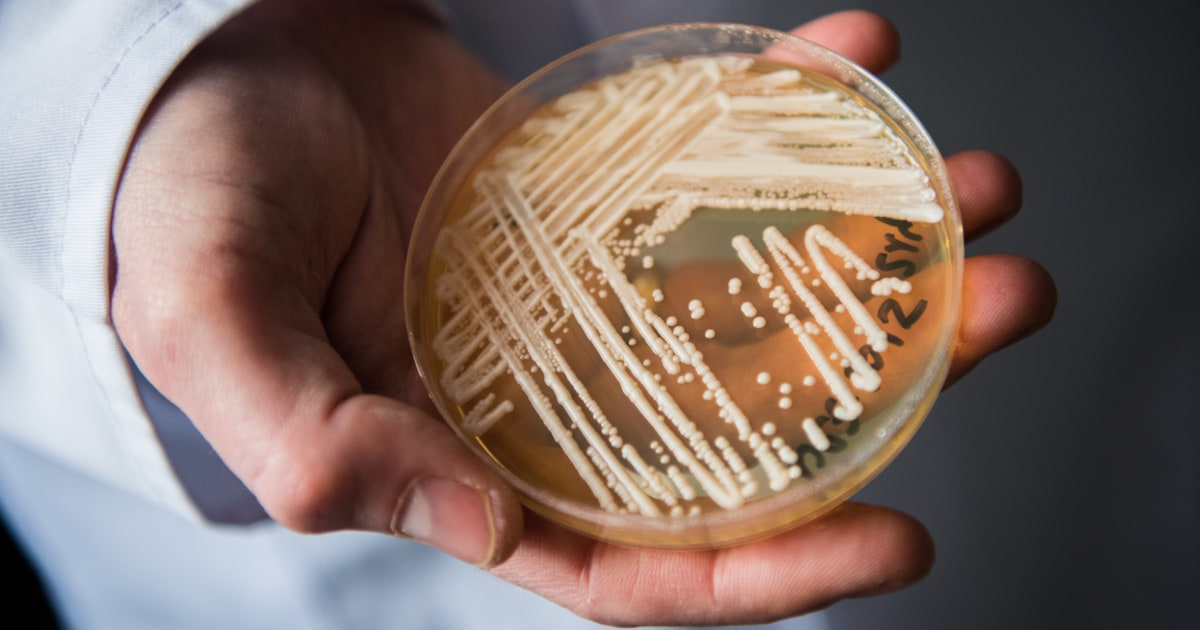

U.S. health officials have confirmed a troubling milestone in the nation’s ongoing battle against emerging infectious threats: more than 7,700 cases of a dangerous, drug-resistant fungus were reported across the United States in 2025. The organism, known as Candida auris, has become one of the most alarming pathogens confronting hospitals and public health agencies, earning the label of “superbug” due to its resilience, persistence, and resistance to standard treatments.
In an update posted on December 27, the Centers for Disease Control and Prevention (CDC) reported that 7,702 confirmed cases of Candida auris were recorded in 30 states during the past year. The figures reflect both clinical infections and cases in which individuals were found to be colonized by the fungus, meaning it was present on their skin or in their bodies even if it had not yet caused active disease.
The burden of infections has been especially heavy in several states. Nevada and California each reported more than 2,000 cases, making them the hardest-hit regions in the country. Texas confirmed more than 800 cases, while Illinois reported approximately 600. Other states across the Midwest, Northeast, and Southeast also saw steady increases, underscoring that C. auris is no longer confined to isolated areas but has become a nationwide public health concern.
First identified in Asia in 2009 and detected in the United States in 2015, Candida auris is a type of yeast that spreads primarily in health care environments. The CDC has warned that it can move rapidly through hospitals, nursing homes, and long-term care facilities, where patients are often immunocompromised and medical equipment is shared. Unlike many other fungal infections, C. auris can survive on surfaces for extended periods, making it exceptionally difficult to eliminate from clinical settings.
Compounding the threat is the organism’s resistance to treatment. C. auris is described as “multidrug-resistant,” meaning that the antifungal medications commonly used to treat yeast infections are often ineffective. In some cases, the fungus is resistant to all three major classes of antifungal drugs, leaving clinicians with few therapeutic options.
A comprehensive review released in December 2025 by researchers at the Hackensack Meridian Center for Discovery and Innovation in New Jersey emphasized that the fungus is not only spreading worldwide but is becoming more formidable. The authors described C. auris as “extremely successful in colonizing human skin,” noting that molecular evidence suggests the proteins in its cell wall attach “like a kind of glue” to human cells and even to non-living surfaces such as bed rails, doorknobs, and medical devices.
This ability allows the fungus to persist in hospital rooms long after an infected patient has left, increasing the risk that the next occupant will become exposed. Traditional cleaning agents may not be sufficient to eradicate it, forcing health care facilities to adopt specialized disinfection protocols.
Despite its aggressive spread, experts emphasize that C. auris does not travel through the air. According to the Cleveland Clinic, “experts don’t believe C. auris spreads through the air.” Instead, it is typically carried on the skin and transmitted from person to person or through contact with contaminated objects and surfaces. This means that proper hand hygiene, protective equipment, and rigorous environmental cleaning remain the most effective defenses against transmission.
Symptoms of a C. auris infection vary depending on where the fungus establishes itself in the body. Common signs include fever, chills, fatigue, rapid heart rate, low blood pressure, and abnormally low body temperature. These symptoms can be difficult to distinguish from other serious infections, particularly in critically ill patients who may already be experiencing similar complications.
When the fungus enters the bloodstream, the consequences can be severe. Bloodstream infections can lead to sepsis, shock, organ failure, and death. The Hackensack Meridian researchers noted that while the human immune system attempts to combat C. auris, the organism has evolved sophisticated mechanisms to evade immune defenses. Its unique cell wall provides “advantages in drug resistance and host interactions” compared with other fungal species.
The stakes are high. The review, published in Microbiology and Molecular Biology Reviews, reported that C. auris infections are “frequently associated with high mortality rates,” often exceeding 50 percent even when antifungal therapy is administered. Patients who are colonized—meaning the fungus is present without causing active disease—remain at risk of developing invasive infections later, particularly if they undergo surgery, require catheters, or experience a decline in immune function.
Another major challenge is diagnosis. C. auris is often misidentified by standard laboratory tests, leading to delays in initiating appropriate treatment and in implementing infection-control measures. In busy clinical environments, these delays can allow the fungus to spread unnoticed.
Public health authorities view the rising numbers as a warning sign. The CDC has emphasized the need for early detection, rapid reporting, and strict infection-control practices. Many hospitals now screen high-risk patients upon admission, especially those transferred from facilities known to have C. auris outbreaks. When a case is identified, patients are often isolated, and staff are required to use gowns and gloves to prevent further transmission.
Researchers argue that these measures, while essential, are not sufficient on their own. The Hackensack Meridian team highlighted the urgent need to develop new antifungal drugs with broader and more reliable activity against resistant fungi. They also called for improvements in diagnostic testing to ensure that C. auris can be identified quickly and accurately.
Beyond drugs and diagnostics, scientists are exploring immune-based therapies and even vaccines for patients at highest risk. While vaccines against fungal infections are still largely experimental, experts believe they may eventually become a critical tool in protecting vulnerable populations, such as those undergoing chemotherapy, organ transplant recipients, and residents of long-term care facilities.
The global dimension of the problem further complicates the response. C. auris has been reported on every inhabited continent, and surveillance systems vary widely between countries. In many resource-poor regions, cases may go undetected due to limited laboratory capacity. The researchers stressed that better surveillance, particularly in less developed nations, is essential to understanding how the fungus spreads and evolves.
“Taken together, these data underscore the need to develop novel antifungal agents with broad-spectrum activity against human fungal pathogens, to improve diagnostic tests, and to develop immune- and vaccine-based adjunct modalities for the treatment of high-risk patients,” the authors wrote.
They added that future efforts must also focus on raising awareness about fungal diseases more broadly. Compared with bacteria and viruses, fungi have historically received less attention in public health planning, despite the fact that they cause millions of serious infections worldwide each year.
“All these developments should help improve the outcomes and prognosis of patients afflicted by opportunistic fungal infections,” the researchers concluded.
For now, health officials urge vigilance. The surge in Candida auris cases in 2025 reflects not only the organism’s adaptability but also the strain placed on health care systems in the wake of recent years of pandemic pressure. As hospitals continue to grapple with staffing shortages and high patient volumes, maintaining strict infection-control practices becomes even more challenging—and more essential.
The rise of C. auris serves as a reminder that the next public health crisis does not always arrive in the form of a new virus. Sometimes, it emerges quietly, spreading from bed to bed in hospital wards, exploiting every weakness in the system. The numbers released by the CDC make clear that this threat is no longer hypothetical. It is already here, and it is growing.

Emily Johnson is a critically acclaimed essayist and novelist known for her thought-provoking works centered on feminism, women’s rights, and modern relationships. Born and raised in Portland, Oregon, Emily grew up with a deep love of books, often spending her afternoons at her local library. She went on to study literature and gender studies at UCLA, where she became deeply involved in activism and began publishing essays in campus journals. Her debut essay collection, Voices Unbound, struck a chord with readers nationwide for its fearless exploration of gender dynamics, identity, and the challenges faced by women in contemporary society. Emily later transitioned into fiction, writing novels that balance compelling storytelling with social commentary. Her protagonists are often strong, multidimensional women navigating love, ambition, and the struggles of everyday life, making her a favorite among readers who crave authentic, relatable narratives. Critics praise her ability to merge personal intimacy with universal themes. Off the page, Emily is an advocate for women in publishing, leading workshops that encourage young female writers to embrace their voices. She lives in Seattle with her partner and two rescue cats, where she continues to write, teach, and inspire a new generation of storytellers.